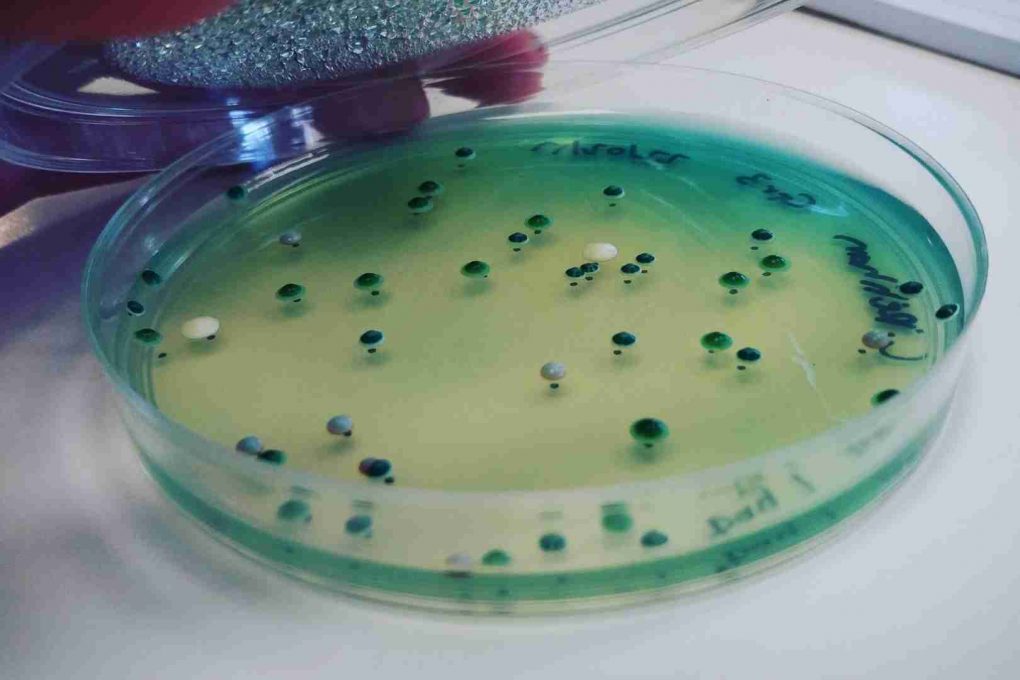

Nuestro planeta está lleno de vida. Esta afirmación que a priori puede sonar un tanto cliché, genérica y extraída de viejas y empolvadas enciclopedias de ciencias naturales, es mucho más profunda de lo que puede parecer a simple vista. Incluso en los rincones más inhóspitos y recónditos de la tierra, podemos encontrar formas de vida con adaptaciones de lo más inusuales.
Tan solo piensa en un desierto, donde las temperaturas son extremas y el agua muy escasa. Nuestra visión sesgada de la realidad nos induciría a pensar que, en estas circunstancias, la probabilidad de encontrar un ser vivo es casi tan reducida como la de recibir un número premiado de la lotería. Sin embargo, pasamos algo por alto; existen seres vivos que poseen el mismo don de la ubicuidad que se le atribuye a Dios desde un punto de vista cristiano, los microorganismos.
¿Qué es Microbiología y cómo se originó?
Si queremos comprender mejor a estos pequeños seres, debemos de familiarizarnos con la ciencia que se encarga de estudiarlos, la microbiología. Se trata de una ciencia relativamente joven (sus inicios datan de mediados del siglo XVII) que nació de la mano de los primeros microscopios. Es a Anton van Leeuwenhoek a quien se le atribuye el calificativo de padre de la microbiología. Este científico, mediante la ayuda de un rudimentario microscopio, fue capaz de visualizar por primera vez a unas criaturas invisibles para el ojo humano contenidas en una gota de agua. Desde el más puro desconocimiento los bautizó como “animánculos”.
Durante los años venideros, se gestó la idea (bastante acertada, por cierto) de que los procesos de descomposición y putrefacción estaban mediados por la acción de los microorganismos. Sin embargo, esta idea surgió de la mano de la generación espontánea, es decir, que los seres vivos se originan por una reorganización de la materia dependiendo de las circunstancias. No fue hasta el año 1861, en pleno siglo XIX, que el científico Louis Pasteur con sus experimentos consiguió desechar por completo la idea de la generación espontánea y demostró que la descomposición de los alimentos dependía de un contacto entre los microbios del ambiente y el alimento en sí.
Posteriormente, se fueron descubriendo más características propias de los microorganismos. Por ejemplo, su estructura celular, su fisiología, las rutas metabólicas que llevan a cabo... Y se desarrollaron las primeras clasificaciones taxonómicas. En definitiva, podemos decir que la microbiología es la ciencia que estudia a los microorganismos y todos los procesos en los que estos están involucrados. Esta ciencia se ha ido diversificando a lo largo de los siglos, de forma que han ido surgiendo diversas ramas que se han centrado en cuestiones más específicas.
La Microbiología y la biotecnología
En la actualidad, la microbiología ha cobrado mucha importancia desde un punto de vista biotecnológico. Nuestro conocimiento nos ha llevado a utilizar a los microorganismos con diversos fines. No hay que olvidar que la producción de pan, vino, cerveza y otros productos alimenticios fermentados como el yogurt y el kéfir, depende en gran medida de la acción microbiana. Paradójicamente, muchos de estos alimentos ya se producían en la antigüedad sin que se llegase a intuir siquiera la existencia de los microorganismos.
Pero los microorganismos no solo tienen un elevado potencial desde el punto de vista de la producción de alimentos. Algunas especies presentan rutas metabólicas complejas que les permiten obtener energía, nitrógeno o poder reductor a partir de compuestos que para el ser humano u otros organismos pueden resultar potencialmente tóxicos o mortales. Por ejemplo, las pertenecientes a los géneros Pseudomonas y Rhodococcus entre muchos otros. Esto plantea la posibilidad de utilizarlos para retirar del medio ambiente sustancias derivadas de la nociva activad humana, como por ejemplo el cianuro o el 2-4-dinitrofenol.
Los microorganismos: ¿Amigos o enemigos?
La mayoría de los microorganismos existentes en el planeta son inocuos o beneficiosos para el ser humano. Sin embargo, siempre que se menciona la palabra microbio, la mayoría la percibimos con una connotación negativa. Si bien tan solo menos del 2% de los microorganismos existentes son causantes de enfermedades, sus efectos sobre nuestro organismo hacen que desarrollemos hacia ellos cierta reticencia.
¡Y no es para menos! Determinadas enfermedades víricas o bacterianas pueden llegar a ser crónicas o mortales. No hay que olvidar, por ejemplo, al agente causal de la peste negra (Yersinia pestis), al virus del ébola, el virus del VIH, o el SARS-CoV-2, agente causal del COVID-19, que tantos muertos ha dejado por el camino en esta terrible pandemia.
En conclusión, hay que temer a los microorganismos en su justa medida. A fin de cuentas, nos aportan más beneficios que perjuicios. De no ser por los microorganismos simbióticos que viven en nuestro colon, por ejemplo, la vida humana no sería posible. ¿Te gustaría aprender más sobre Microbiología? ¡No te pierdas nuestro Máster de Formación Permanente en Microbiología!
Categorizado en:
Biosanitario